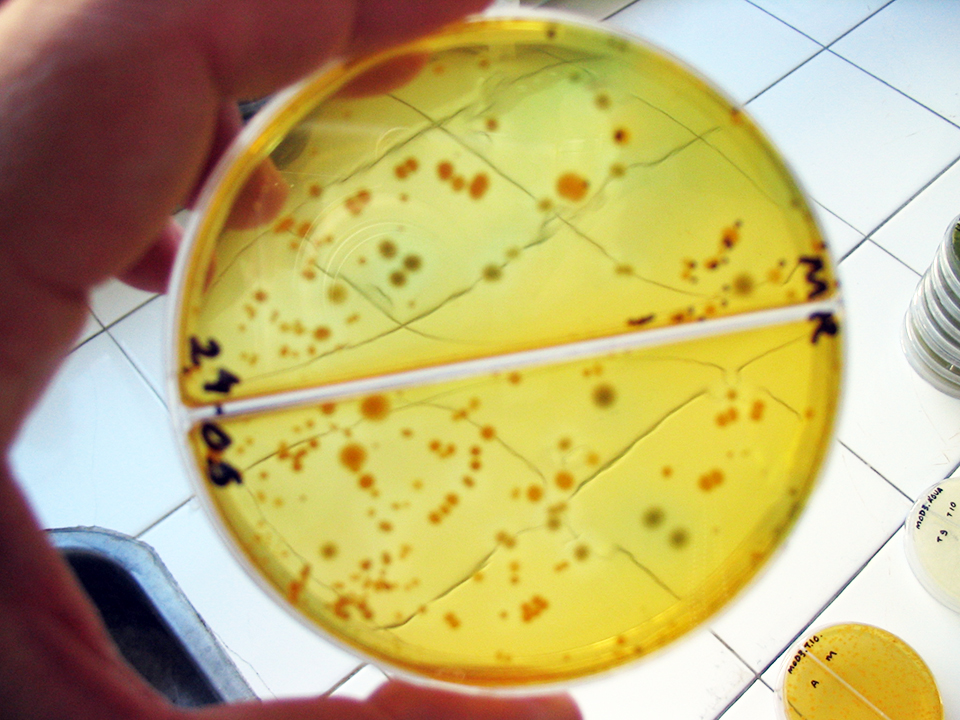

Responsibilities for farmers, feed manufacturers

With today’s market globalization, it is very important to keep pace with new regulations and international codes of practice. Producers, nutritionists, and feed mill managers in the aquaculture industry should be aware of such developments for proper planning and management of their businesses. It may be even more important to stay ahead of regulations by adopting responsible and ethical food production and trade practices.
Antimicrobial resistance and aquaculture
Currently, a “Code of Practice to Minimize and Contain Antimicrobial Resistance” is under review by the FAO/WHO Codex Alimentarius Commission. Further consideration of the proposed code will be given at the 15th session of the Codex Committee on Residues of Veterinary Drugs in Foods in October. Jumping ahead and looking at some of the responsibilities contemplated for producers of food animals may be beneficial for the aquaculture industry.
As proposed, producers would be responsible for implementing health programs to prevent disease outbreaks at their farms. If disease outbreaks occur, they must be dealt with diligently. Assistance from a veterinarian is recommended.
Following are important points for aquafarmers to consider to minimize antimicrobial resistance and maximize efficacy when using antibiotics.
Preventive medicine
First, a health contingency plan should be prepared with a veterinarian. It should outline all pertinent preventive measures that improve farm biosecurity and hygienic conditions, and avoid the introduction and spread of pathogens. When an outbreak appears, sick animals should be isolated when possible, and dead and dying animals disposed of appropriately.
Proper antibiotic use

When a bacterial disease is present in a population of cultured aquatic animals, the most effective method to control it is the adequate use of antibiotics. Specific treatment decisions consider the individual antibiotics; bacterial sensitivity; and treatment duration, dose, and means of administration. They should always comply with all regulations that pertain to the product used and species treated.
In Europe, the only antimicrobials that can be used are those authorized by the European Committee for Veterinary Medicinal Products of the European Agency for the Evaluation of Medicinal Products. In the United States, the Center for Veterinary Medicine of the Food and Drug Administration plays a similar role.
Combinations of antibiotics can provide synergistic or additive effects. However, the application of various products can also have antagonistic effects. Antibiograms are a highly recommended tool to avoid the use of products that are ineffective against insensitive bacteria.
A veterinary or other qualified animal health professional must prescribe doses based on the manufacturer labels that cover the shortest period of time possible for effective treatment. Adequate laboratory records should be maintained and made available to the veterinarian, who can evaluate any bioresistance for certain antimicrobials.
Antimicrobials can be administered via immersion or baths, in food, and other means. Treatment via feed is the most recommended method in aquaculture, but it must be considered that sick animals may have lost appetite and feed ingestion may not be sufficient for adequate treatment.
Farms should always comply with recommended withdrawal periods to ensure that maximum residue limits in animal-derived foods do not pose a risk for consumers.
It is very important to keep adequate records of all veterinary medicinal products used, including:
- Antimicrobial product, active substance, and batch number
- Supplier name
- Prescribing veterinarian name
- Application date and dose, period of administration
- Identification of animals that receive treatment
- Clinical conditions treated
- Withdrawal period
- Treatment results, laboratory test results.
Manufacturing practices
When manufacturing aquafeed that includes antimicrobials, it is important to follow strict guidelines to remove residues left in the feed production line, because these can cause cross contamination of the next feed batch produced. When fed to shrimp or fish, feeds contaminated with low doses of antimicrobial agents can cause bacteria to become resistant to the treatment product.
The best way to avoid cross contamination is to flush all the equipment and lines exposed to the antimicrobial with an ingredient of fine particle size that has high carrying capacity. Flush frequency depend on several factors.
Production schedules
At times, production managers may be forced to make a single short flush run to continue production. This is a major problem in feed mills where other terrestrial animal feeds are manufactured.
In many countries, feeds for swine and poultry that contain cocktails of antimicrobials are produced on the same production lines aquatic feeds are manufactured. To reduce the risk of cross contamination, many commercial feed producers have installed dedicated aquafeed lines.
Equipment design
If plants have many screw conveyors, the problem of cross contamination can be exacerbated because flushing may not remove all residues of the antimicrobial. Therefore, drag conveyors may be more appropriate to ensure cleanliness of the line.
Aspiration system
Plants with aspiration systems should change bag filters after runs with formulations that include antimicrobials, for fine particles entrapped in them can be passed to the next run when the fines are recycled.
Processing equipment
Although sometimes overlooked, all equipment and units of production that come in contact with the medicated feed should be thoroughly cleaned. Pellet mills have areas where material accumulates. These areas are the walls of the preconditioner, chute from preconditioner to pellet mill, pellet mill chute and doors.
Because the environment is hot and humid in these areas, removal with a flushing mix is almost impossible. Therefore, the equipment should be scraped and thoroughly cleaned prior to the next run. Similar treatments should be applied to other equipment with areas of material accumulation, including postpellet cookers, dryers, coolers, bucket elevator boots and coaters.
Packaging
Packaging areas, the last feeds pass through prior to being stored or dispatched, should also be flushed. The flushing procedure must start at the first piece of equipment (mixer) in contact with the product and go to the last.
Condition of equipment
All equipment that contacts feed should be in an optimal state of performance. For instance, if mixer paddles are worn out, the antimicrobial may not be homogenously mixed with other ingredients and thus not delivered in the right amount to the target species. This is critically important when the size of the target species is considered.
In-line quality control
To further ensure that flushing is effective and post-antimicrobial production is safe, quality control personnel should appropriately inspect production lines. If necessary, they should collect samples for antibiograms to determine the presence of antimicrobials.
Physical attributes of aquafeed
Processing conditions should be optimal to reduce water leakage of the antimicrobials. In the pelleting process, much care must be taken to produce feed with the highest possible water stability. Encapsulation of antimicrobials may offer an alternative to unwanted leaching, ensuring that the target species consumes the target amount prescribed by the veterinarian.
Recommendations for feed mills
Following are some general recommendations that feed mill managers should put into practice to minimize antimicrobial resistance in cultured aquatic species:
- Do not use prohibited antimicro-bials. Maintain an up-to-date list of prohibited antimicrobials for each species of interest.
- Produce feed medicated with antimicrobials only with the support of a veterinarian prescription.
- Comply with specified dosages defined by veterinarian prescriptions.
- Avoid cross contamination of feeds by purging production lines each time medicated feed is produced.
- Do not use out-of-date antimicrobials.
- Store antimicrobials according to specifications.
- Keep records for all medicated feeds produced, including the antimicrobial names, active substances, batch numbers, supplier names, and prescribing veterinarians.Also record the dates and batch numbers of medicated feed production, drug quantities used and feed buyers.
Conclusion
Antimicrobials are a very important tool for controlling infectious diseases in both animals and humans. Thus, the responsible use of these agents is vital to maintain their availability and affects against disease when absolutely required. This information will help us look into the future, search for alternative management practices and technologies conducive to less or no antimicrobial use, and drive us to make appropriate adaptions for the benefit of a responsible aquaculture industry.
(Editor’s Note: This article was originally published in the October 2004 print edition of the Global Aquaculture Advocate.)
Now that you've reached the end of the article ...
… please consider supporting GSA’s mission to advance responsible seafood practices through education, advocacy and third-party assurances. The Advocate aims to document the evolution of responsible seafood practices and share the expansive knowledge of our vast network of contributors.
By becoming a Global Seafood Alliance member, you’re ensuring that all of the pre-competitive work we do through member benefits, resources and events can continue. Individual membership costs just $50 a year.
Not a GSA member? Join us.
Authors
-
Mario Velasco, Ph.D.
Enaca Seafood C.A.
Guayaquil, Ecuador[99,101,46,116,101,110,46,97,117,99,101,64,111,99,115,97,108,101,118,109]
-
Eugenio Bortone, Ph.D., PAS, Dpl. ACAN
Frisco, Texas, USA
-
Ignacio de Blas, DVM, Ph.D.
Veterinary Faculty
University of Zaragoza
Zaragoza, Spain
Related Posts

Health & Welfare
Antimicrobial resistance: Aquaculture to humans, humans to aquaculture?
The transfer of resistance from an aquaculture pathogen into a human enteric bacterium has been demonstrated in research and may be happening in the real-world environment.

Health & Welfare
Antimicrobial resistance: complex, unavoidable
Resistance to antibiotics is unavoidable because it is an aspect of bacterial evolution. Resistant microflora have been observed in water that has not had recent contact with antimicrobial agents.

Health & Welfare
Antibiotic-resistant bacteria, part 1
No antimicrobial agent has been developed specifically for aquaculture applications. However, some antibiotic products used to treat humans or land-based animals have been approved for use at aquaculture facilities.
Health & Welfare
Flaws in reporting antimicrobial resistance
Improving the methodology of antimicrobial resistance testing and related controls, and the implementation of laboratory ring tests could lead to more reliable information.


